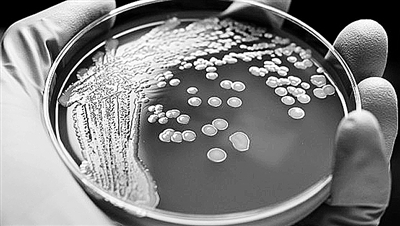
1469757308484094981.jpg GC9y-fxunyyf6063534.jpg

"刀枪不入"的超级细菌有了克星!来自鼻腔的抗生素能杀死它
来源:科技日报 日期:2016-07-29
“住”在我们鼻腔中的一种细菌可生产出能杀死超级细菌的新药。德国图宾根大学的一个研究小组称,他们在人类鼻腔内发现的一种名为“路邓葡萄球菌”的细菌,具有独特功效,在被制成抗生素后不但能杀灭超级细菌,还不易产生耐药性。该发现有助研发出新型疗法,让此前“刀枪不入”的超级细菌闻风丧胆。
抗生素曾被称为抗菌素,在大量使用多年后,也让细菌产生了极强的抗药性。以耐甲氧西林金黄色葡萄球菌(MRSA)、抗万古霉素肠球菌(VRE)等为代表的超级细菌开始逐渐嚣张。面对这种病菌,普通杀菌药物毫无作用,人类几乎陷入了无药可用的窘境。
大部分抗生素取自土壤活菌,但就像开采过度的矿山一样,如今要在那里发现新的抗生素越来越难。科学家们不得不将目光转向包括人体在内的动植物。人体内存在着各种微生物,鼻腔也不例外。科学家发现,不少人鼻腔中存在着金黄色葡萄球菌,但真正致病的却并不多,这一现象一直让科学家疑惑不解。
德国图宾根大学的安德烈亚斯·佩舍尔和他的同事发表在最新一期《自然》杂志上的论文称,在新的研究中,他们用在鼻腔中发现的路邓葡萄球菌产生出了一种名为“路邓素(Lugdunin)”的抗生素,其对包括MRSA在内的多种革兰氏阳性菌表现出强有力的抗菌活性,而且还不易在金黄色葡萄球菌内产生耐药性。该结果已经在小鼠实验中得到了证实。
研究人员还检查了187名住院病人的鼻腔分泌物,发现在携带路邓葡萄球菌的病人中,感染金黄色葡萄球菌的比例为5.9%,而在未携带路邓葡萄球菌的病人中,该比例高达34.7%。这表明,在人体鼻腔中,路邓葡萄球菌似乎有助于抑制金黄色葡萄球菌。研究人员称,由于处于研发中的新型抗生素不多,该研究具有一定的临床意义,而且凸显了人体微生物作为新型抗生素潜在来源的价值。